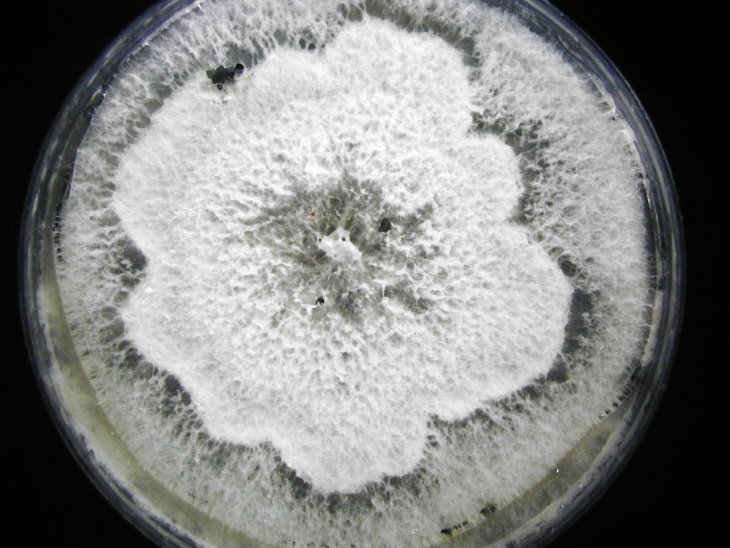
菌落型態：白色花形菌落，上有黑色圓形菌核

收件日期:980601
發生地點:臺東
病蟲害名稱:桃子菌核病 Sclerotinia cineria (Bon.) Schr.
病徵判斷

褐色水浸狀病斑
菌落型態:白色花形菌落,上有黑色圓形菌核
防治方法
◎ 由病徵及型態判斷為菌核病 Sclerotinia cineria (Bon.) Schr.。
◎ 藥劑防治:50%賽普洛水分散性粒劑1,000倍;42.2%?硫?水懸劑1000倍;22.8%菲克利腐絕水懸劑1,000倍; 24.9%待克利乳劑2,000倍;37%護矽得乳劑10,000倍。










